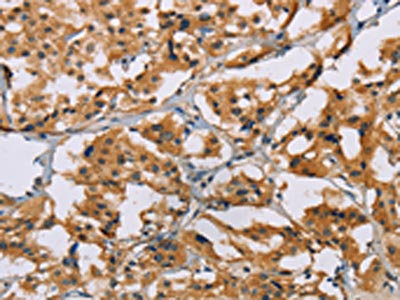

-
中文名稱:NRN1兔多克隆抗體
-
貨號:CSB-PA061766
-
規格:¥1100
-
圖片:
-
The image on the left is immunohistochemistry of paraffin-embedded Human thyroid cancer tissue using CSB-PA061766(NRN1 Antibody) at dilution 1/50, on the right is treated with fusion protein. (Original magnification: ×200)
-
The image on the left is immunohistochemistry of paraffin-embedded Human brain tissue using CSB-PA061766(NRN1 Antibody) at dilution 1/50, on the right is treated with fusion protein. (Original magnification: ×200)
-
-
其他:
產品詳情
-
Uniprot No.:
-
基因名:NRN1
-
別名:Neuritin 1 antibody; Neuritin antibody; NRN antibody; Nrn1 antibody; NRN1_HUMAN antibody; OTTHUMP00000015989 antibody; RP3 380B8.2 protein antibody
-
宿主:Rabbit
-
反應種屬:Human,Mouse,Rat
-
免疫原:Fusion protein of Human NRN1
-
免疫原種屬:Homo sapiens (Human)
-
標記方式:Non-conjugated
-
抗體亞型:IgG
-
純化方式:Antigen affinity purification
-
濃度:It differs from different batches. Please contact us to confirm it.
-
保存緩沖液:-20°C, pH7.4 PBS, 0.05% NaN3, 40% Glycerol
-
產品提供形式:Liquid
-
應用范圍:ELISA,IHC
-
推薦稀釋比:
Application Recommended Dilution ELISA 1:2000-1:5000 IHC 1:50-1:200 -
Protocols:
-
儲存條件:Upon receipt, store at -20°C or -80°C. Avoid repeated freeze.
-
貨期:Basically, we can dispatch the products out in 1-3 working days after receiving your orders. Delivery time maybe differs from different purchasing way or location, please kindly consult your local distributors for specific delivery time.
-
用途:For Research Use Only. Not for use in diagnostic or therapeutic procedures.
相關產品
靶點詳情
-
功能:Promotes neurite outgrowth and especially branching of neuritic processes in primary hippocampal and cortical cells.
-
基因功能參考文獻:
- NRN1 is expressed more extensively in melanoma than in normal melanocytes and healthy tissue. Secreted NRN1 seems to play a role also in earlier phases of melanoma development as we can discover NRN1 over-expression to be associated to primary melanoma PMID: 27901477
- results suggest that DTNBP1 and NRN1 genes show a joint effect on the risk for schizophrenia spectrum disorders. Although the precise mechanism underlying this effect is unclear, the fact that these genes have been involved in synaptic maturation, connectivity and glutamate signalling suggests that our findings could be of value as a link to the schizophrenia aetiology. PMID: 27855309
- NRN1 is associated with depressive symptoms and executive function in a non-clinical sample. Our results also suggest that the role of NRN1 seems to be modulated by BDNF. PMID: 28107668
- On analysis of the expression of NRN1 in SMA patients for the first time, NRN1 could be a potential modifier gene PMID: 27279027
- Ca(2+)/calcineurin (CaN)/nuclear factor of activated T-cells (NFAT) c4 axis is required for neuritin-induced Kv4.2 transcriptional expression and potentiation of IA densities in cerebellum granule neurons. PMID: 27307045
- (i) NRN1 variability is a shared risk factor for both schizophrenia-spectrum disorders (SSD) and bipolar disorders (BPD), (ii) NRN1 may have a selective impact on age at onset and intelligence in SSD. PMID: 26700405
- Data indicate that neuritin not only plays an important role in the nervous system but also has an effect on the migration, senescence, proliferation, and viability of stem cells PMID: 26208391
- Neuritin is reduced in the brains of Alzheimer's disease (AD) patients. PMID: 25101829
- MiR-204 promotes apoptosis in oxidative stress-induced rat Schwann cells by suppressing neuritin expression PMID: 25036738
- we found neuritin is overexpressed in astrocytoma, which may be an important factor in tumorigenesis and progression of astrocytoma PMID: 20405246
- Data show that SMN and HuD form a complex in spinal motor axons, and that both interact with cpg15 mRNA in neurons. PMID: 21652774
- NRN1 polymorphisms have roles in fluid intelligence in schizophrenia PMID: 19569075
- CPG15 and CPG15-2 perform similar cellular functions but may play distinct roles in vivo through their cell-type- and tissue-specific transcriptional regulation PMID: 18265009
顯示更多
收起更多
-
亞細胞定位:Cell membrane; Lipid-anchor, GPI-anchor. Cell junction, synapse.
-
蛋白家族:Neuritin family
-
數據庫鏈接:
Most popular with customers
-
-
YWHAB Recombinant Monoclonal Antibody
Applications: ELISA, WB, IHC, IF, FC
Species Reactivity: Human, Mouse, Rat
-
Phospho-YAP1 (S127) Recombinant Monoclonal Antibody
Applications: ELISA, WB, IHC
Species Reactivity: Human
-
-
-
-
-